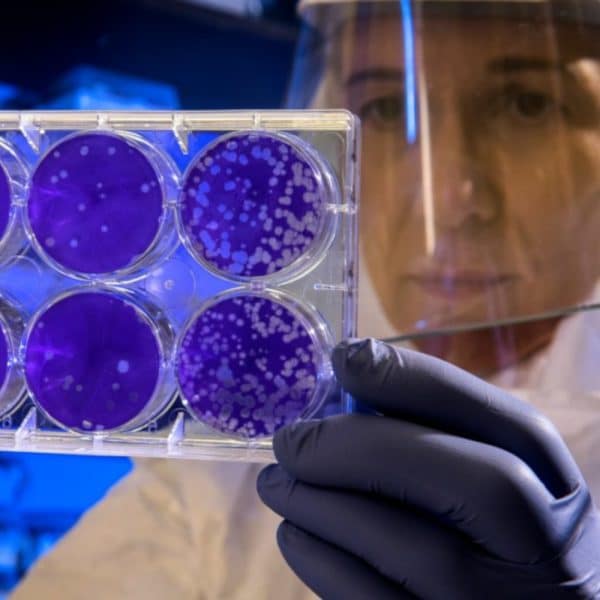

Study for Advanced Pancreas Cancer treated by Oncothermia

This clinical study focused on the use of oncothermia, a combination of conventional therapies with a novel treatment, for patients with aggressive and common pancreas cancer (PCA). The study took place in two centers and showed exceptional survival benefits compared to historical data, demonstrating the feasibility and potential of oncothermia for PCA treatment.
Impfstoffe, die auf Dendritische Zellen zur Bekämpfung von Prostatakrebs abzielen: Verbindung zwischen der Immunantwort

Diese Studie konzentrierte sich auf die Immuntherapie mit aus Blut gewonnenen Dendritischen Zellen (DZs) bei Patienten mit kastrationsresistentem Prostatakrebs.
Autologous dendritic cells and activated cytotoxic T‐cells

Breast cancer is the most common cancer in women worldwide. Researchers have developed a new treatment using dendritic cells (DCs) and cytotoxic T lymphocytes to target residual cancer cells that often cause tumor recurrence and spreading to other parts of the body.
WT1-pulsed DCV Combined with Chemotherapy

The study tested a WT1-DC vaccine combined with chemotherapy in surgically treated pancreatic cancer patients.
Kombination von Chemotherapie mit adoptiver Zelltherapie

Diese Studie untersuchte eine Kombination aus Therapie mit dendritischen Zellen (DZ) und Zytokin-induzierten Killerzellen (CIK) mit Hochdosis-Chemotherapie (HDC) bei Patientinnen mit metastasiertem Brustkrebs (MBC).
Clinical use of Dendritic Cells for Cancer Therapy
Clinical use of Dendritic Cells for Cancer Therapy Dendritic Cell Vaccine Contact Us Summary Dendritic cell-based immunotherapy is safe and can induce antitumour immunity, even in patients with advanced disease. findings from emerging research indicate that dendritic cell-based vaccination might improve survival, advocating implementation of alternative endpoints to assess the true clinical potency of dendritic […]